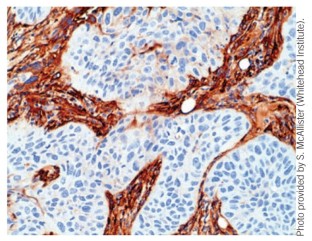

Coevolution in the tumor microenvironment (original) (raw)
- News & Views
- Published: May 2008
Nature Genetics volume 40, pages 494–495 (2008)Cite this article
- 1282 Accesses
- 78 Citations
- 8 Altmetric
- Metrics details
The progression of carcinomas to high-grade malignancies is accompanied by profound histological changes in the tumor-associated stroma. Although previous studies have suggested that mesenchymal cells of the stroma undergo genetic alterations during this progression, a new study now provides evidence that strongly contradicts this theory of stromal cell coevolution.
This is a preview of subscription content, access via your institution
Relevant articles
Open Access articles citing this article.
Access options
Subscribe to this journal
Receive 12 print issues and online access
$259.00 per year
only $21.58 per issue
Buy this article
- Purchase on SpringerLink
- Instant access to the full article PDF.
USD 39.95
Prices may be subject to local taxes which are calculated during checkout
Additional access options:
Figure 1: Islands of neoplastic epithelial cells (light blue nuclei) are surrounded by a myofibroblast-rich stroma (dark brown).
References
- Qiu, W. et al. Nat. Genet. 40, 650–655 (2008).
Article CAS Google Scholar - Dvorak, H.F. N. Engl. J. Med. 315, 1650–1659 (1986).
Article CAS Google Scholar - Lakhani, S.R. et al. J. Pathol. 189, 496–503 (1999).
Article CAS Google Scholar - Moinfar, F. et al. Cancer Res. 60, 2562–2566 (2000).
CAS PubMed Google Scholar - Wernert, N., Locherbach, C., Wellmann, A., Behrens, P. & Hugel, A. Anticancer Res. 21, 2259–2264 (2001).
CAS PubMed Google Scholar - Kurose, K. et al. Nat. Genet. 32, 355–357 (2002).
Article CAS Google Scholar - Patocs, A. et al. N. Engl. J. Med. 357, 2543–2551 (2007).
Article CAS Google Scholar - Fukino, K., Shen, L., Patocs, A., Mutter, G.L. & Eng, C. J. Am. Med. Assoc. 297, 2103–2111 (2007).
Article CAS Google Scholar - Weber, F. et al. J. Am. Med. Assoc. 297, 187–195 (2007).
Article CAS Google Scholar - Moinfar, F. et al. Mod. Pathol. doi:10.1038/modpathol.2008.28 (8 February 2008).
Article CAS Google Scholar - Allinen, M. et al. Cancer Cell 6, 17–32 (2004).
Google Scholar
Author information
Authors and Affiliations
- Massachusetts Institute of Technology Department of Biology, Robert A. Weinberg is at the Whitehead Institute for Biomedical Research, Ludwig Center for Molecular Oncology, Cambridge, Massachusetts 02142, USA. weinberg@wi.mit.edu,
Robert A Weinberg
Rights and permissions
About this article
Cite this article
Weinberg, R. Coevolution in the tumor microenvironment.Nat Genet 40, 494–495 (2008). https://doi.org/10.1038/ng0508-494
- Issue date: May 2008
- DOI: https://doi.org/10.1038/ng0508-494